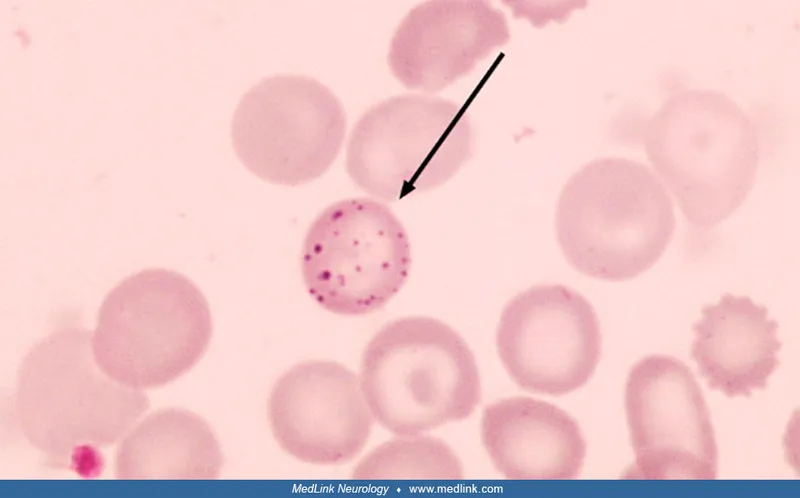
Basophilic stippling in lead poisoning

Air Pollution - Breath of Fresh Toxin
- Key Pollutants: Ground-level ozone ($O_3$), sulfur dioxide ($SO_2$), nitrogen dioxide ($NO_2$), carbon monoxide (CO), lead (Pb), and particulate matter (PM).
- Particulate Matter (PM) Size Effects:
- PM >10 µm: Filtered by the upper airway (nose/pharynx).
- PM <2.5 µm (PM2.5): Reaches alveoli, enters circulation, and triggers systemic inflammation.
- Mechanisms of Injury:
- CO: Binds hemoglobin with >200x affinity than $O_2$ → carboxyhemoglobin → systemic hypoxia.
- $O_3$, $SO_2$, $NO_2$: Generate free radicals → damage respiratory epithelium.
⭐ Ultrafine particles (PM2.5) are potent cardiovascular risks. They can translocate into the bloodstream, promoting endothelial dysfunction, atherosclerosis, and thrombosis.

Heavy Metal Mayhem - Toxic Rock Stars
- Lead (Pb)
- Sources: Old paint, batteries, contaminated water.
- Patho: Inhibits ferrochelatase & ALA dehydratase → microcytic anemia with basophilic stippling.
- Clinical: Burton's lines (gums), encephalopathy, abdominal colic, wrist/foot drop.
- Mercury (Hg)
- Sources: Contaminated fish (tuna), dental amalgams.
- Clinical: Neuropsychiatric symptoms ("mad as a hatter"), tremors, gingivostomatitis.
- Arsenic (As)
- Sources: Contaminated water (wells), pesticides, wood preservatives.
- Clinical: Acute (garlic breath, rice-water stool); Chronic (hyperkeratosis, neuropathy, cancers).
- Cadmium (Cd)
- Sources: Cigarettes, batteries.
- Clinical: Obstructive lung disease, kidney damage → Itai-itai disease.
⭐ Arsenic exposure is strongly associated with squamous cell carcinoma of the skin, lung cancer, and angiosarcoma of the liver.
Chemical & Tobacco Injury - Everyday Exposures
- Heavy Metals: Interfere with enzymatic functions by binding to sulfhydryl groups.
| Toxin | Common Sources | Key Presentation |
|---|---|---|
| Lead | Old paint, batteries | Anemia, wrist/foot drop, lead lines (gums, bones) |
| Mercury | Fish, dental amalgams | CNS damage, renal toxicity (Minamata disease) |
| Arsenic | Pesticides, contaminated water | Skin hyperkeratosis, stocking-glove neuropathy |
| Cadmium | Batteries, contaminated soil | Obstructive lung disease, renal toxicity |
- **Carcinogens:** Polycyclic aromatic hydrocarbons, nitrosamines.
- **Systemic Effects:** ↑ platelet aggregation, ↓ oxygen transport (CO), direct endothelial injury.
⭐ High-Yield: Tobacco smoke carcinogens (e.g., polycyclic aromatic hydrocarbons) are metabolized by CYP450 enzymes, leading to DNA adducts that are fundamental to carcinogenesis.

Physical Agents - When Physics Hurts
- Mechanical Trauma: Abrasion (scrape), contusion (bruise), laceration (tear), incision (cut), puncture.
- Thermal Injury:
- Burns: Depth determines severity. Complications: hypovolemic shock, sepsis (📌 Pseudomonas aeruginosa), hypermetabolism.
- Hyperthermia: Heat cramps → exhaustion → stroke (core temp >40°C).
- Hypothermia: Vasoconstriction, ice crystal formation.
- Electrical Injury: Severity depends on amperage and path. AC is more dangerous than DC (tetany). Causes burns, v-fib, respiratory arrest.
- Radiation Injury: Ionizing radiation damages DNA (direct or free radicals). Affects rapidly dividing cells (GI, bone marrow).

⭐ Electrical burns can cause rhabdomyolysis, leading to myoglobinuria and acute kidney injury.
High‑Yield Points - ⚡ Biggest Takeaways
- Air pollution, especially PM₂.₅, exacerbates cardiopulmonary diseases; ozone causes free radical lung injury.
- Lead poisoning impairs heme synthesis, causing microcytic anemia and neurotoxicity (wrist/foot drop).
- Arsenic and mercury are potent neurotoxins; arsenic is also linked to skin and lung cancers.
- Asbestos is the only known cause of mesothelioma and leads to pleural plaques and fibrosis.
- Ionizing radiation causes DNA damage, with hematopoietic tissue and GI mucosa being highly sensitive.
- Cigarette smoke is the leading cause of preventable death, strongly linked to lung cancer and COPD.
Unlock the full lesson and continue reading
Signup to continue reading this lesson and unlimited access questions, flashcards, AI notes, and more